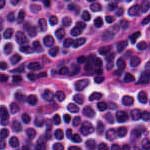

Among all the remarkable things that we humans can do, effortlessly, that takes huge amounts of effort to do any other way; our image pattern recognition is perhaps the most awesome.

Original Image
|

Poor Compression
|

Difference
|
Good Compression
|

Difference
|
I was just struck by this in working with various compression schemes for images. The best way for me to evaluate a compression routine is to load an image in Photoshop, then load an image which has been compressed and decompressed with the routine in question, and create a new image which is the "difference" between them. I can then visually tell right away how well the compression routine worked. This is much better and much more informative than writing a program to perform a detailed comparison between the two images.
Not only does this tell me quickly how well the routine worked - the degree of artifacts introduced by the compression - but it tells me what kind of artifacts are introduced. Does the routine introduce false edges? Does it attenuate areas of high contrast? Does it smear detail? Does it affect all color channels equally? Does it have problems with very light areas, or very dark? The only reason I can discern these things so easily is that my personal pattern recognizer is so good. Human vision is amazing. It can pick up edges easily, with no effort required. It can detect subtle differences in contrast, across a very high range of intensity. It can compare two regions of high-frequency detail and tell them apart.
If you look at the images to the right, you can easily see the "poor compression" is inferior to the "good compression". Your pattern recognition is that good. You might not realize why; but looking at the difference images, you have quantitative confirmation, as well as information about the types of artifacts (note all the little horizontal lines!) Writing a program to compare the images and find these artifacts would be non-trivial.
As part of Aperio's approach to Automating Pathology, we've created a lot of amazing tools to perform pattern recognition on very large images. These tools are much faster and much more quantitative than anything a human can do. But their qualitative abilities are vastly inferior. In fact, a big part of the technique we use is to automate the laborious pre-processing of images to optimize the use of human pattern recognition, just as "differencing" with Photoshop does.
| 



